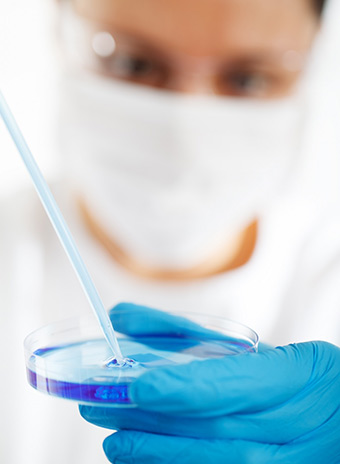
project

Introducing Summerport Surgery Center
Summerport Surgery Center is a multi-specialty surgery center specializing in Urology, Gynecology, General, Colorectal, and GI procedures. Our goal is to offer the finest quality medical care that is cost effective in a personalized setting. We offer state-of-the-art equipment and highly trained staff to ensure your comfort and safety. We want to make your upcoming visit as comfortable and as pleasant as possible.
Multi-Specialty Surgery
Specialists in Urology, Gynecology, General, Colorectal, and GI procedures.
State-of-the-Art
Offering state-of-the-art systems and surgical procedures